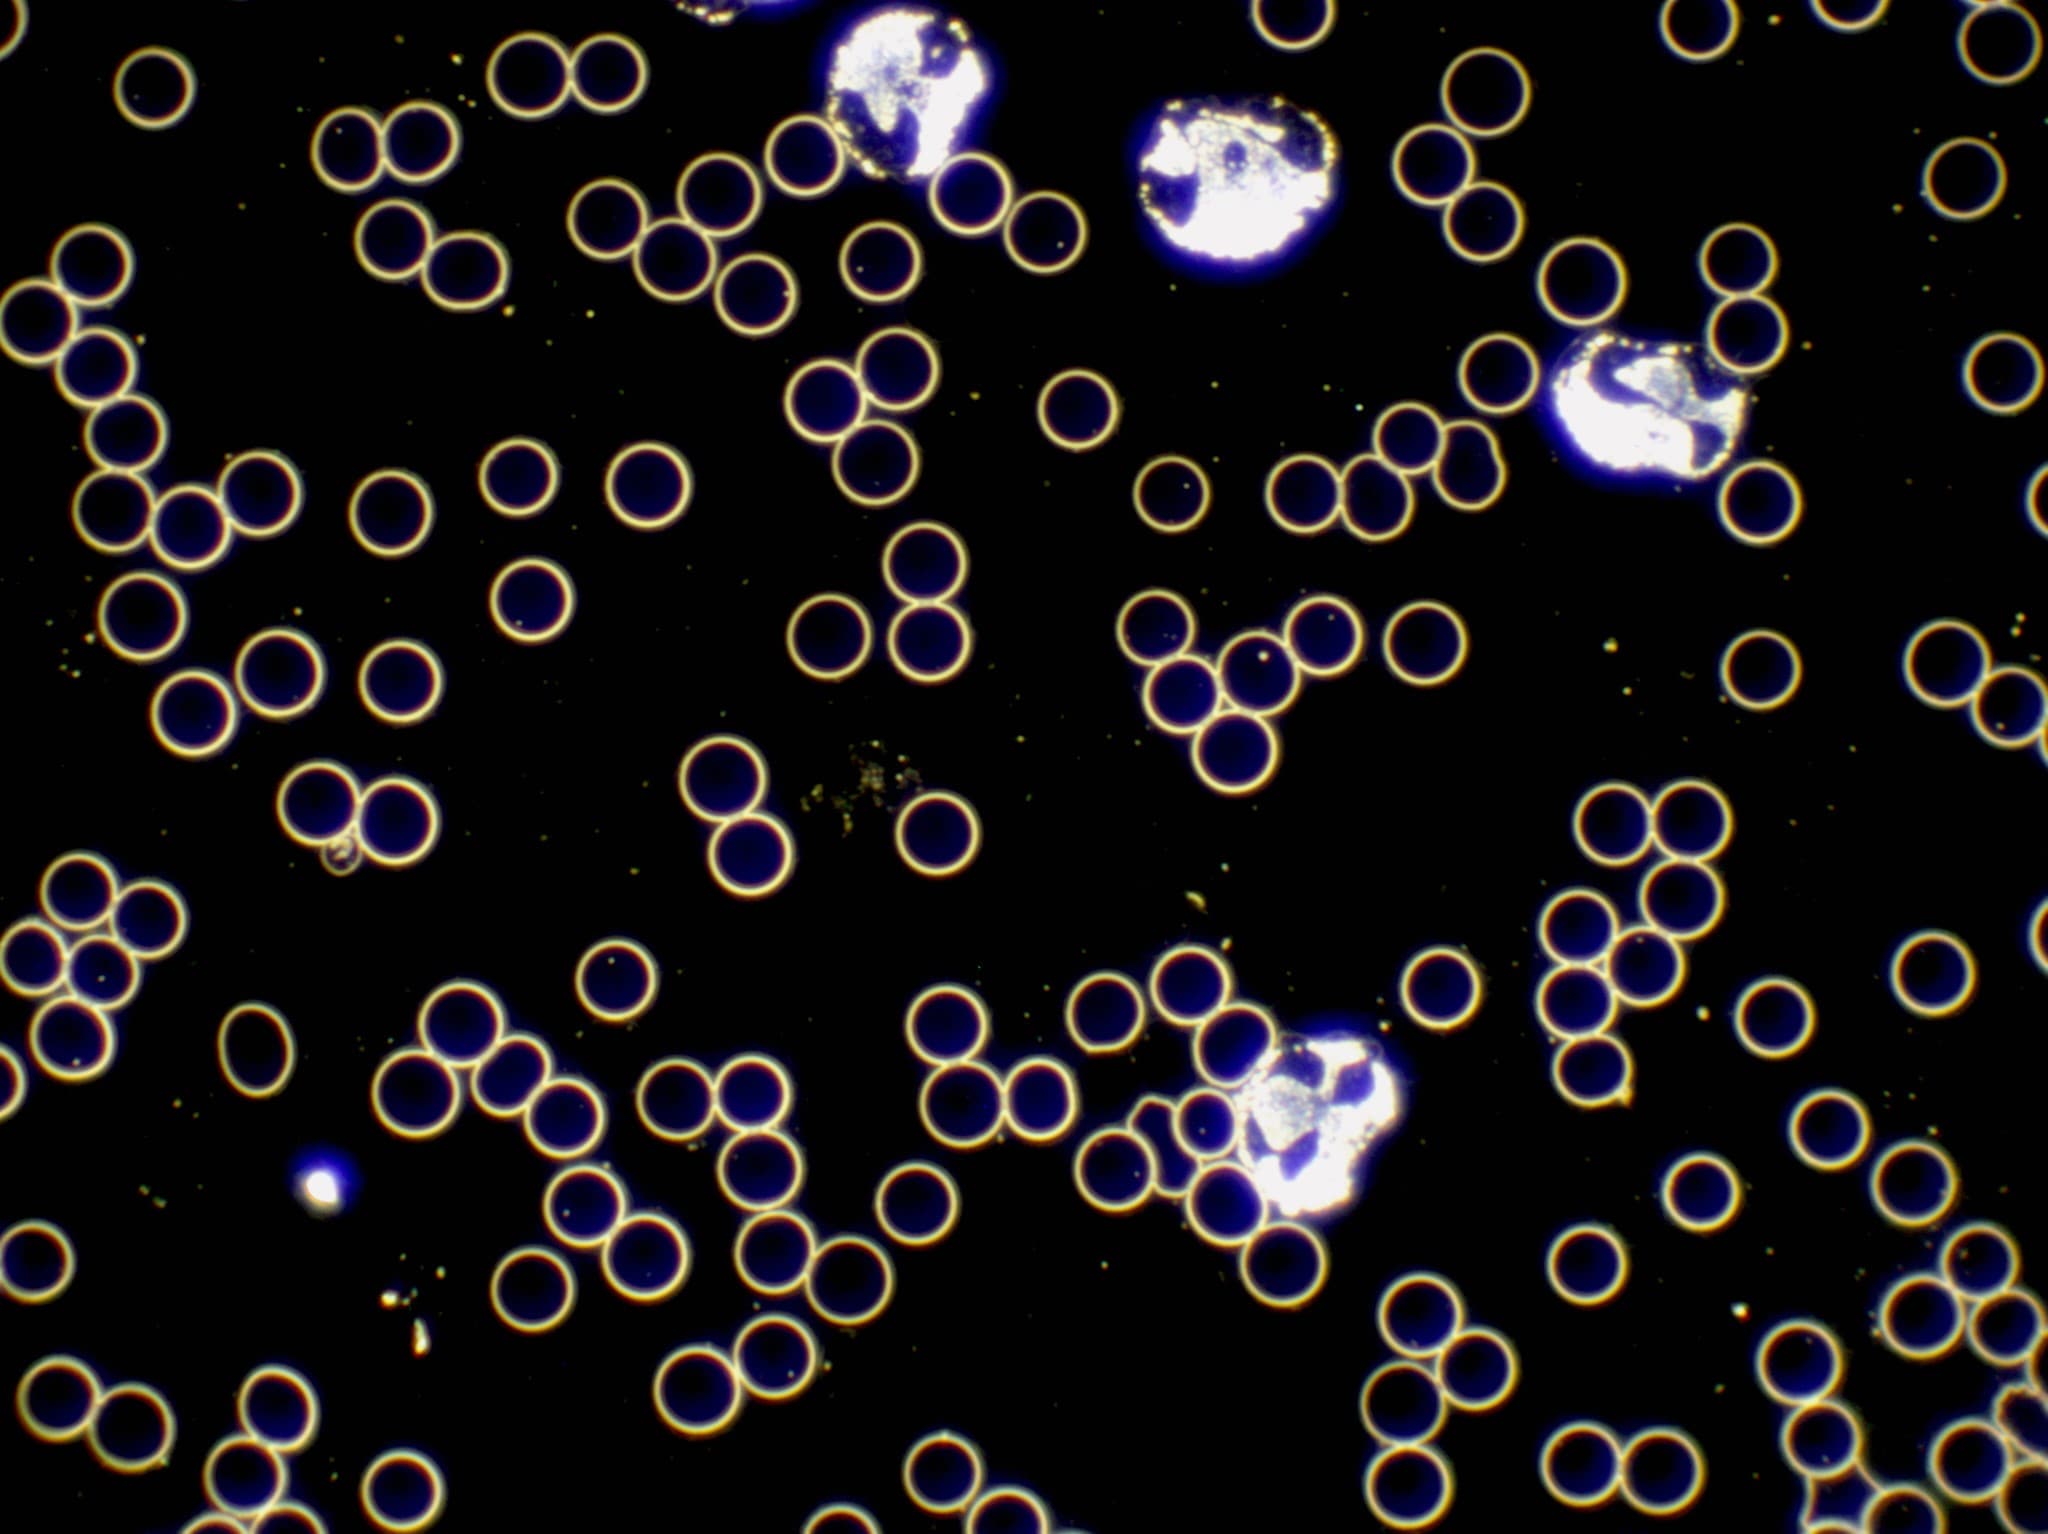
Dunkelfeldmikroskopie
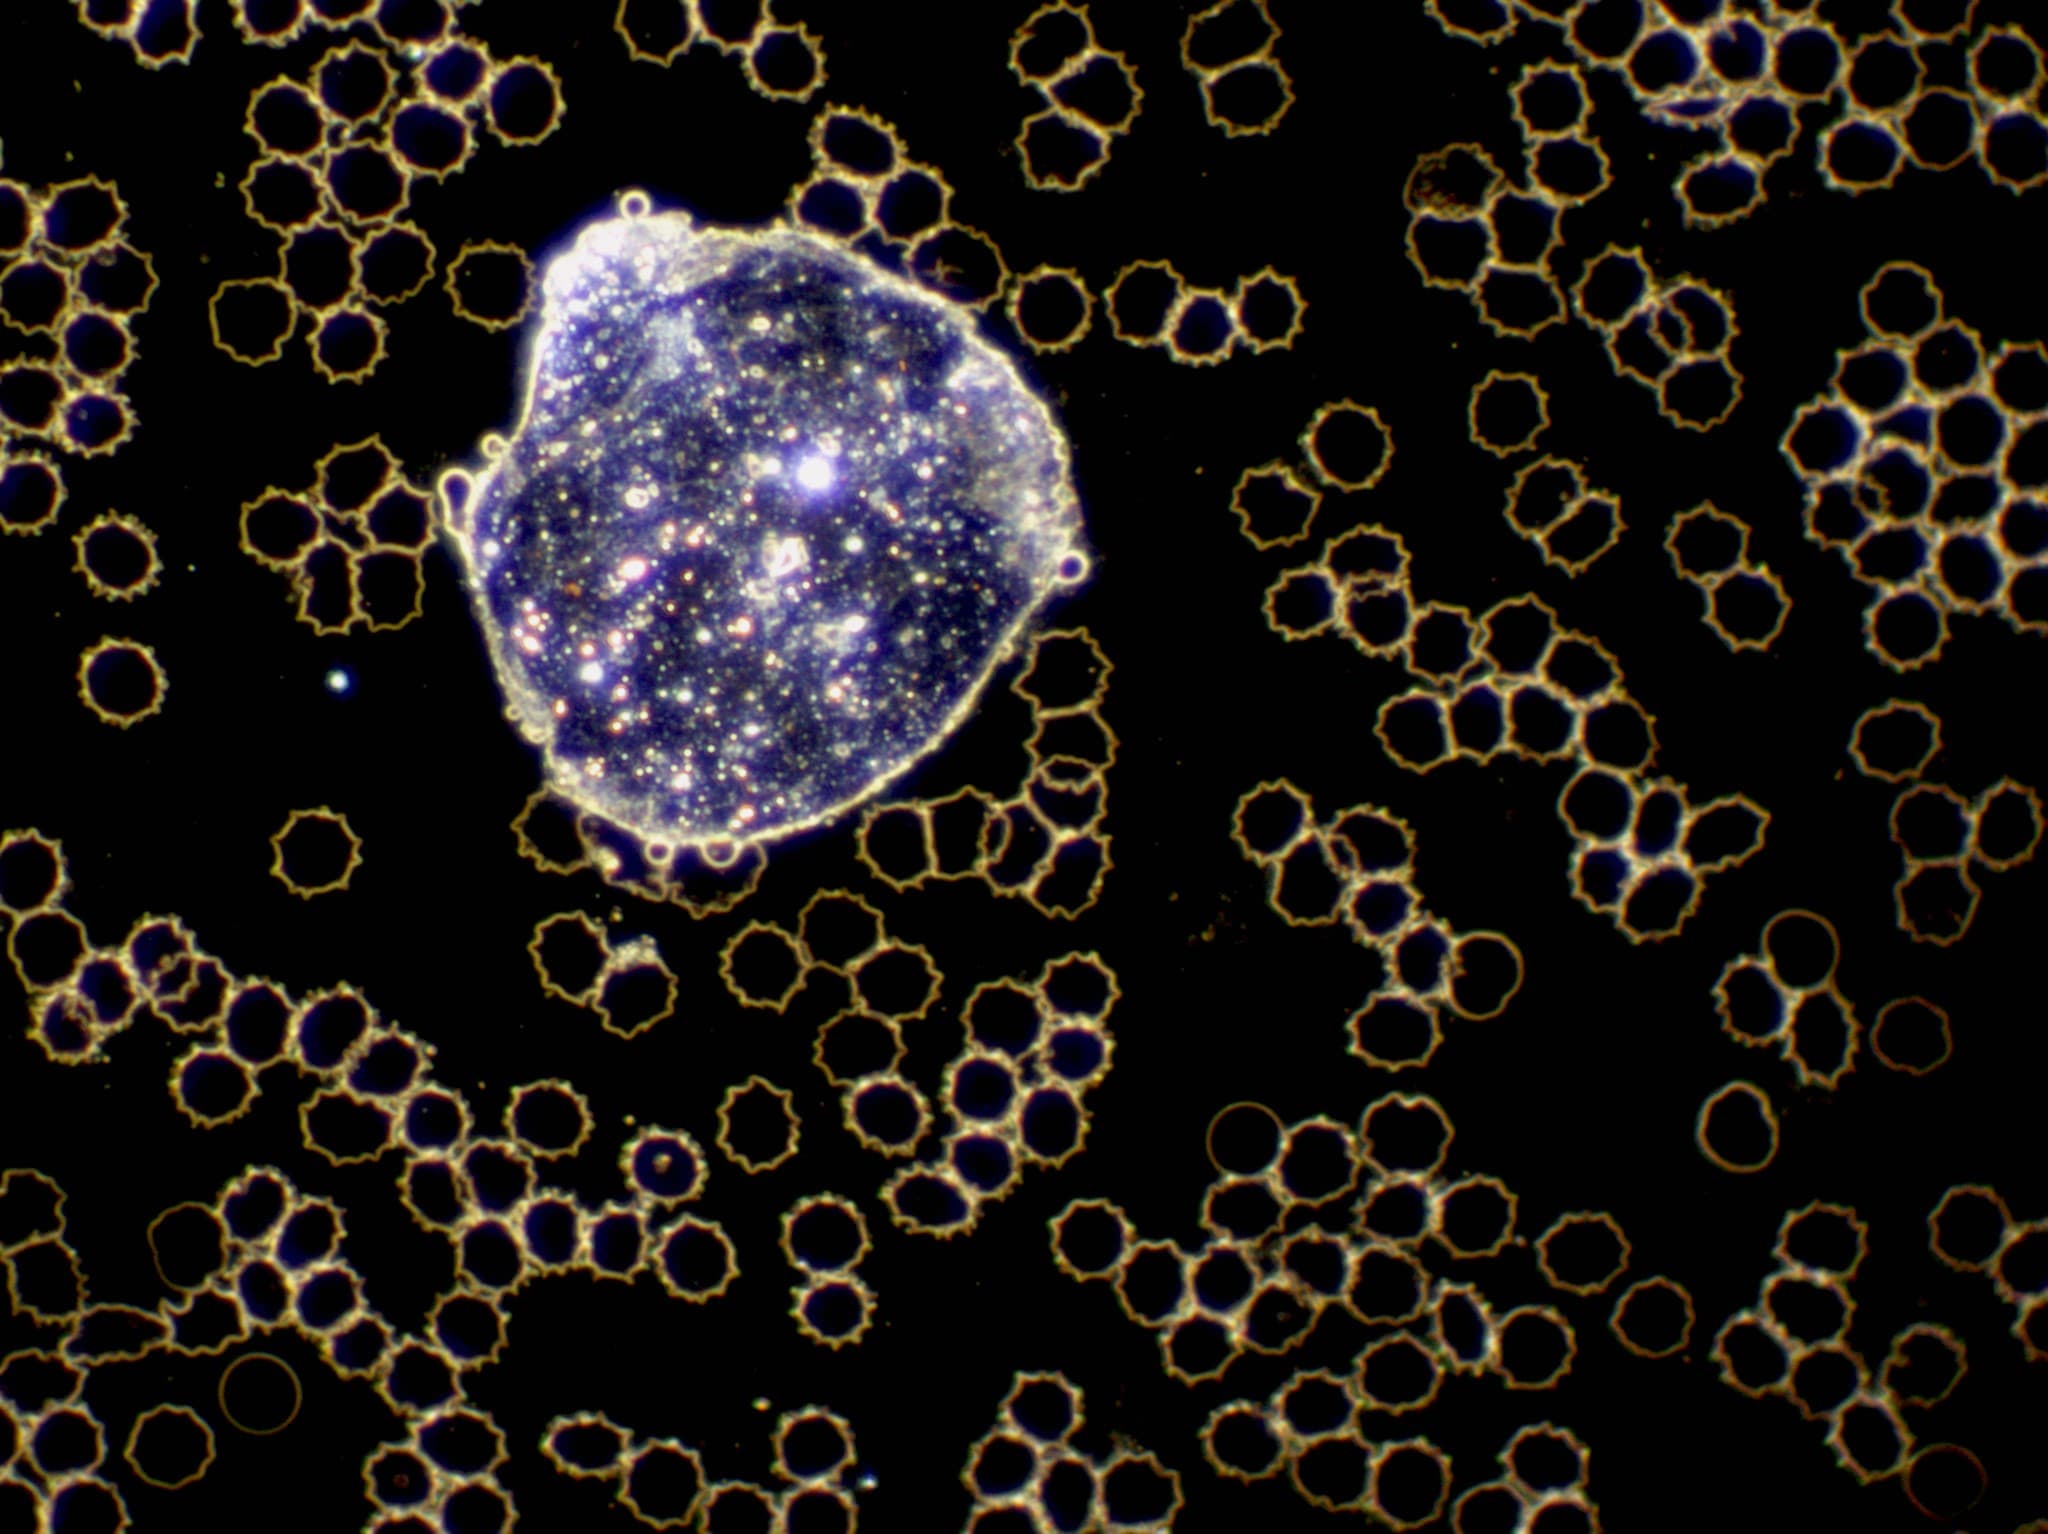
test
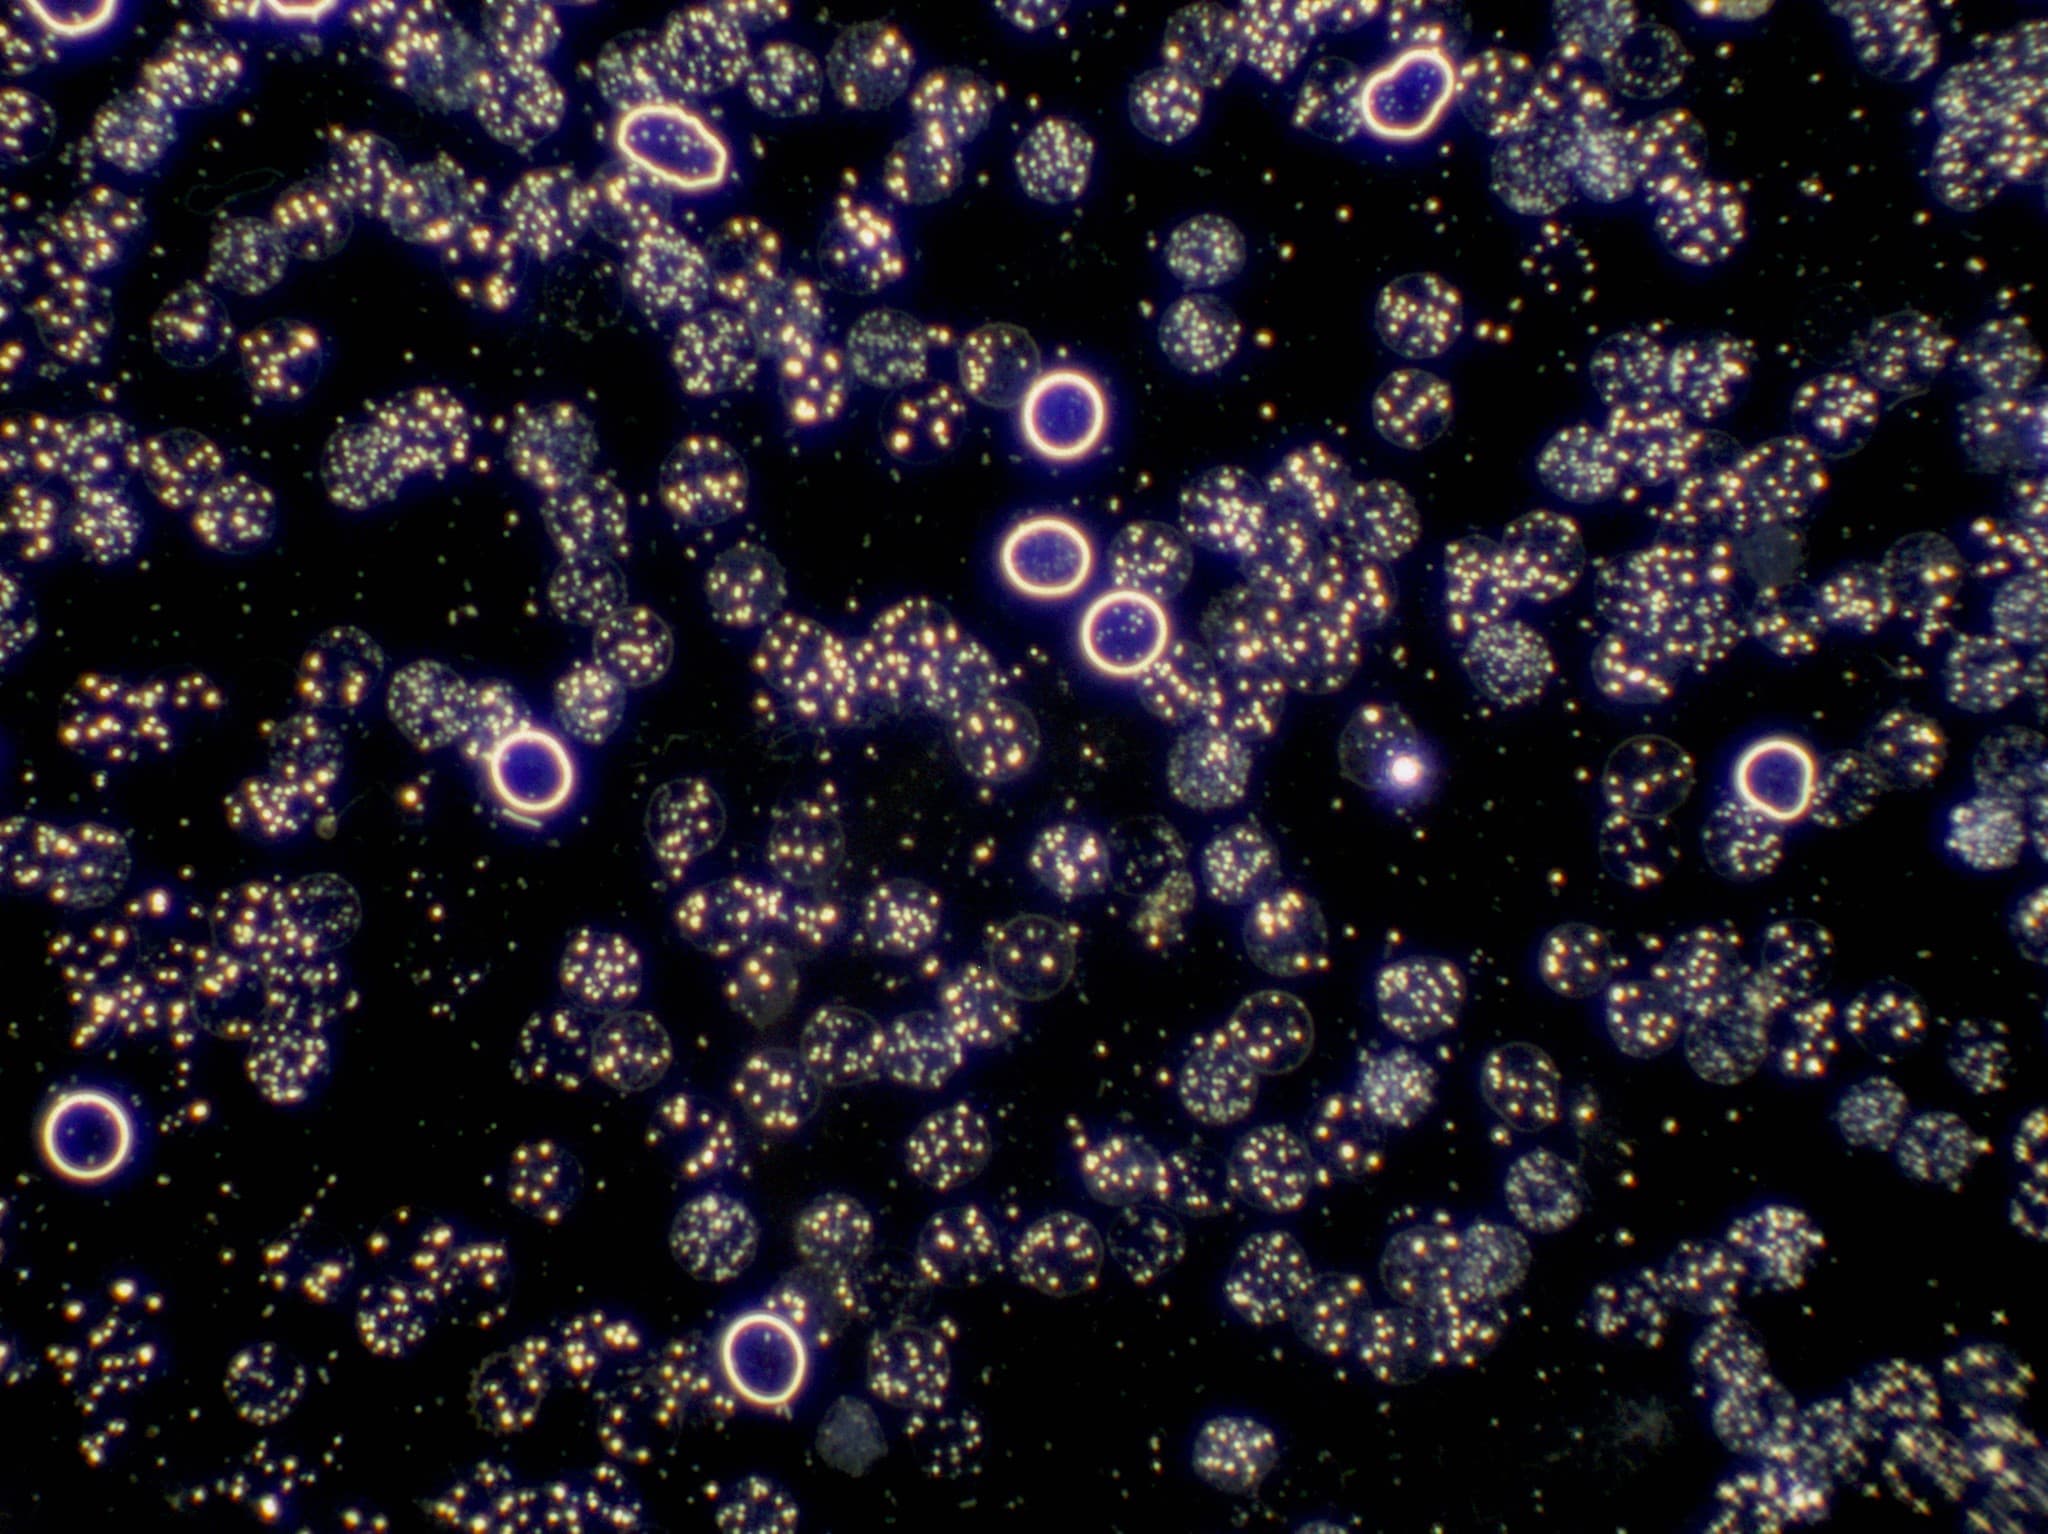
test

Dunkelfeldmikroskopie
Dein Blut ist lebendig.
Es erzählt Geschichten, die Du mit blossem Auge nie sehen würdest. Winzige Zeichen, die verraten, wie es Deinem Körper wirklich geht. Mit der Dunkelfeldmikroskopie schaue ich tief in Dein lebendes Blut und erkenne Ungleichgewichte, lange bevor sie zu Beschwerden werden. Ein einziger Tropfen genügt und Du siehst live am Bildschirm, was in Deinem Körper vor sich geht. Faszinierend, aufschlussreich und der Beginn Deiner ganzheitlichen Gesundheitsvorsorge.
Was ist Dunkelfeldmikroskopie?
Laborwerte sagen Dir, wie viele Blutzellen Du hast. Die Dunkelfeldmikroskopie zeigt, wie lebendig sie sind. Bewegen sich Deine roten Blutkörperchen frei oder verklumpen sie? Arbeiten Deine weissen Blutkörperchen aktiv oder wirken sie träge? Diese Vitalität ist entscheidend für Deine Gesundheit und lässt sich nur im lebenden Blut erkennen.

Früherkennung statt Nachsorge
Die Dunkelfeldmikroskopie ist echte Vorsorge. Sie zeigt Ungleichgewichte und Belastungen, lange bevor sich Beschwerden zeigen. Übersäuerung, Durchblutungsstörungen, geschwächtes Immunsystem, Schadstoffablagerungen: all das wird sichtbar, wenn herkömmliche Laborwerte noch völlig unauffällig sind. So kannst Du rechtzeitig gegensteuern, bevor Krankheit entsteht.

Wenn alte Infektionen sich zeigen
Manche Menschen schleppen chronische Belastungen durch z. Bsp. alte Tuberkulose Kontakte mit sich herum, ohne es zu wissen. Im Dunkelfeld zeigen sich typische mykobakterielle Formationen: lange stäbchenförmige Gebilde, die sich hartnäckig halten. Sie schwächen schleichend das Immunsystem, fördern chronische Erschöpfung und Infektanfälligkeit. Mit entsprechenden traditionellen Arzneimitteln, wie die SANUM Präparate, können diese Altlasten sanft ausgeleitet werden.

Die Kraft der isopathischen SANUM Mittel
Die SANUM Therapie arbeitet mit lebenden Mikroorganismen in apathogener, also ungefährlicher Form. Diese Präparate haben klangvolle Namen: MUCOKEHL reguliert den Mucor racemosus zurück in harmlose Stadien. NIGERSAN wirkt gegen pathogene Aspergillusformen, die bei chronischen Atemwegsbelastungen entstehen. NOTAKEHL greift bei bakteriellen Aufwärtsentwicklungen ein, wenn Penicillium Formen überhandnehmen. SANKOMBI kombiniert mehrere Stämme für tiefgreifende Milieuregulation.
Diese Mittel kämpfen nicht gegen Mikroben. Sie regulieren das Terrain. Sie schieben pathogene Formen sanft zurück in symbiotische Stadien. Dein Körper findet sein Gleichgewicht wieder, ohne dass Erreger vernichtet werden müssen. Das ist der geniale Unterschied zur Schulmedizin. Keine Resistenzen, keine zerstörte Darmflora, keine Nebenwirkungen. Nur sanfte, nachhaltige Regulation von innen heraus. Die Dunkelfeldmikroskopie zeigt genau, welches Präparat Du brauchst.
Weitere Diagnosezeichen im Blut
Neben Zellen und Mikroben erscheinen manchmal kristalline Strukturen. Cholesterinkristalle glitzern wie kleine Diamanten und zeigen Fettstoffwechselstörungen. Harnsäurekristalle deuten auf Gicht Neigung, Nierenschwäche oder zu viel Fleischkonsum. Fibrin Fäden ziehen sich durchs Blut bei erhöhter Gerinnungsneigung. Jedes Detail erzählt eine Geschichte. Nichts im Blut ist Zufall. Alles hat Bedeutung. Und mit dieser Fülle an Informationen erstelle ich Deinen massgeschneiderten Therapieplan.
Wie läuft die Untersuchung ab?
Du kommst nüchtern in die Praxis. Ich entnehme Dir einen winzigen Tropfen Blut aus der Fingerbeere, bringe ihn unter das Dunkelfeldmikroskop und wir schauen gemeinsam auf den Bildschirm. Du siehst Dein lebendes Blut in Echtzeit. Ich erkläre, was wir sehen und was es bedeutet. Die ganze Untersuchung dauert etwa 30 bis 45 Minuten.
Das Terrain ist alles, die Mikrobe ist nichts
A. Béchamp und L. Pasteur prägten im 19. Jahrhundert den Satz: Das Terrain ist alles, die Mikrobe ist nichts. Günter Enderlein bewies es hundert Jahre später mit seiner Dunkelfeldmikroskopie. Erreger sind nicht von aussen eingedrungen. Sie leben seit jeher in uns und verändern ihre Form je nach innerem Milieu. Ein gesundes, basisches, sauerstoffreiches Terrain hält sie klein und nützlich. Ein belastetes, saures, verschlacktes Terrain lässt sie zu Monstern mutieren.
Deshalb behandle ich nie Mikroben. Ich behandle Dein Terrain. Mit basischer Ernährung, Entsäuerung, Entgiftung, Bewegung, Stressreduktion und isopathischen Präparaten schaffen wir ein Milieu, in dem Krankheit keinen Nährboden mehr findet. Das ist echte Heilung. Nicht Symptome wegdrücken, sondern Ursachen verwandeln. Dein Blut zeigt mir live, ob das Terrain sich bessert. Dunkelfeldmikroskopie ist Milieudiagnostik pur.
Therapieerfolge sichtbar machen
Nach 2 bis 3 Monaten schauen wir uns Dein Blut erneut an. Die Veränderungen sind oft verblüffend deutlich. Die Blutzellen bewegen sich freier, die Belastungszeichen haben abgenommen, die Vitalität ist gestiegen. Diese sichtbaren Erfolge motivieren ungemein und zeigen Dir: Dein Körper reagiert. Die Therapie wirkt. Du bist auf dem richtigen Weg.
Ist Dunkelfeldmikroskopie etwas für Dich?
Dunkelfeldmikroskopie eignet sich für jeden, der Gesundheit ernst nimmt. Als Vorsorge bei völlig gesunden Menschen, die wissen wollen, wo sie stehen. Bei chronischer Müdigkeit, Infektanfälligkeit oder diffusen Beschwerden, die kein Arzt einordnen kann. Zur Begleitung naturheilkundlicher Therapien, um Erfolge sichtbar zu machen. Nach schweren Erkrankungen zum Regenerationscheck. Vor grossen Entscheidungen, wenn Du wissen willst, wie robust Dein Körper wirklich ist. Dein Blut erzählt es Dir.
Was Du wissen solltest
- Die Dunkelfeldmikroskopie ist in der Schweizer Schulmedizin nicht anerkannt und ersetzt keine ärztliche Diagnose oder Laboruntersuchung.
- Sie zeigt Ungleichgewichte und Belastungstendenzen, aber keine Krankheiten im medizinischen Sinn.
- Bitte komm nüchtern, ohne Handcreme und lasse Nahrungsergänzungsmittel am Untersuchungstag weg.
- Wasser trinken ist erlaubt und sogar erwünscht.